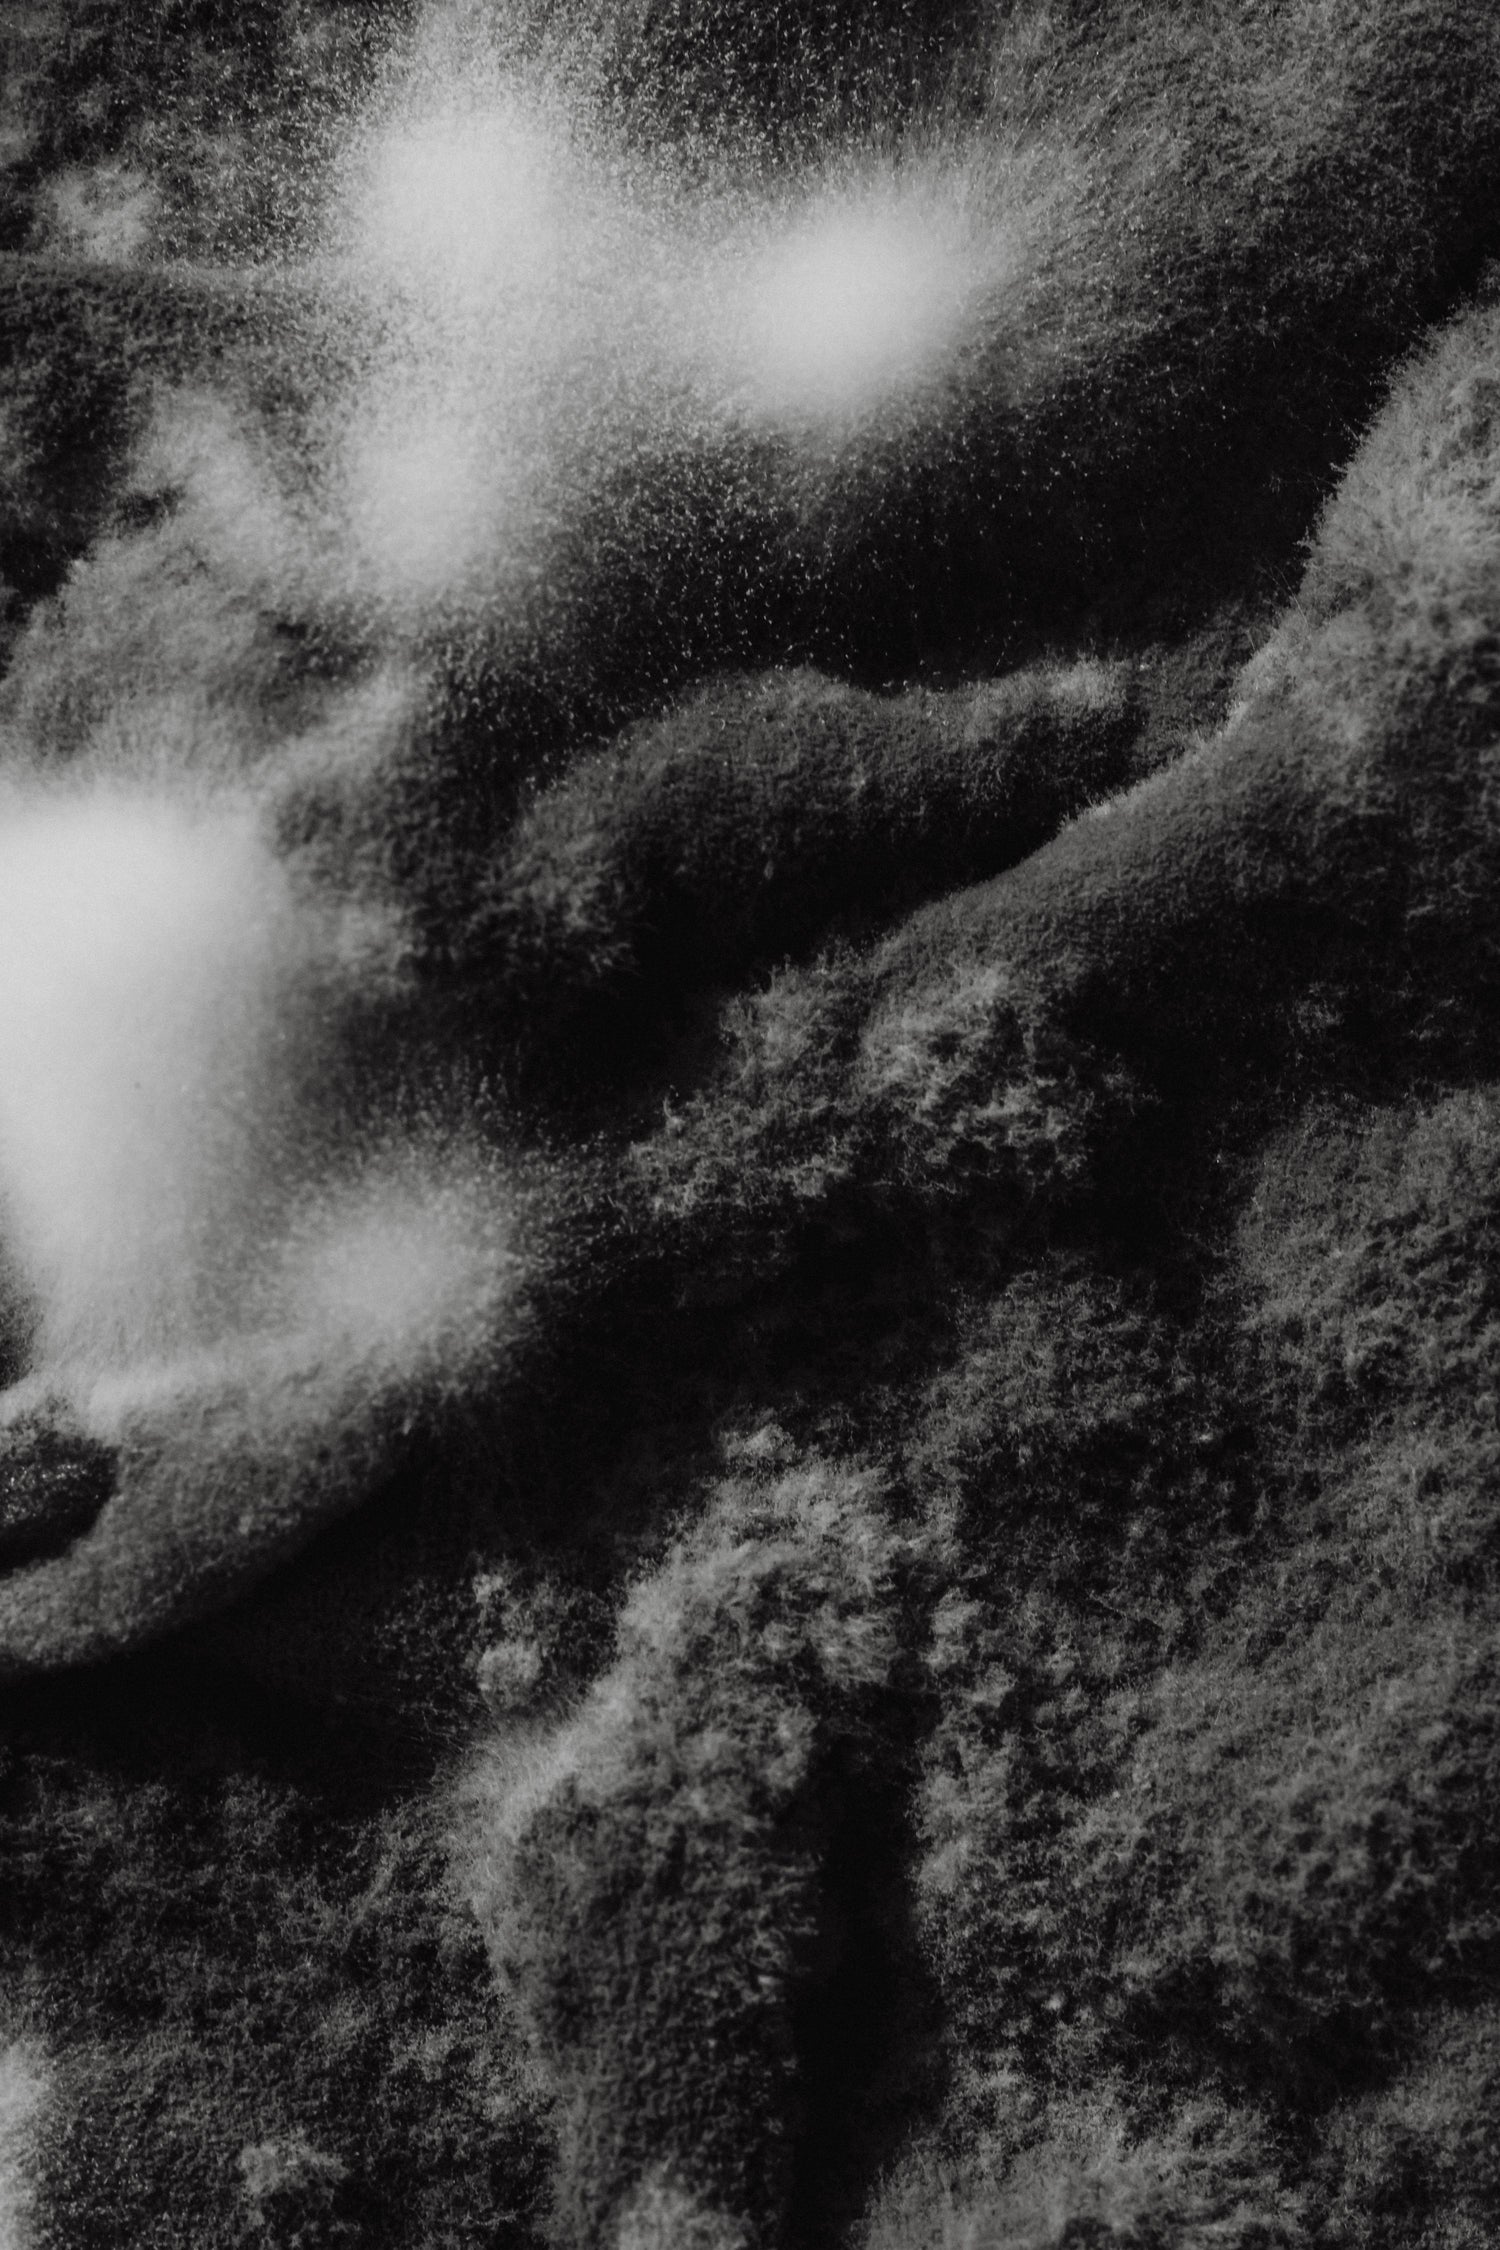

Your Electric Vehicle Journey Starts Here
Connect with EVolution
Have questions about our electric vehicles, accessories, or sustainability initiatives?
Our dedicated team is here to provide you with the information you need to make informed decisions.
Get in Touch

Visit Our Showroom
Step into the world of electric vehicles at our showroom!
Explore our diverse range of in-stock EVs and discover the latest accessories that complement your eco-friendly lifestyle.
Our knowledgeable staff is eager to educate you on the benefits of electric vehicles and help you find the perfect fit for your needs.
Don’t miss out on the chance to experience the future of driving firsthand.
Contact Us directly: +351 960396430
Stay Updated on EV Trends
Subscribe to our newsletter for the latest news on EV technology, sustainability tips, and exclusive offers.
Together, we can drive change.

